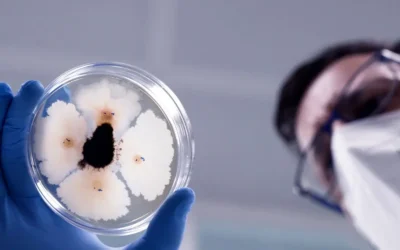
Transferencia tecnológica a partir de investigación básica

Líderes en soluciones nutricionales y bioestimulantes
para una agricultura sostenible.
AEFA
AEFA es una asociación sin ánimo de lucro integrada por fabricantes de fertilizantes, productos especiales de nutrición vegetal, bioestimulantes y microorganismos, con sede e implantación en el territorio español, que trabaja contribuyendo eficazmente al desarrollo y expansión del sector de la fertilización avanzada.
Sostenibilidad
Unas buenas prácticas agrícolas son la base de un respeto por el Medio Ambiente y una de las condiciones precisas de cara a preservar el marco de desarrollo agrícola para las futuras generaciones.
El fuerte compromiso de las empresas de AEFA con la Sostenibilidad queda plasmado en la Estrategia de Sostenibilidad desarrollada dentro del plan de trabajo de la propia Asociación, que impulsa y pone en valor el esfuerzo de todas las compañías en el ejercicio de sus actividades de una manera sostenible social, económica y medioambientalmente.
25
Años de experiencia en el sector de la fertilización avanzada.
Empresas asociadas
%
Ventas Nacionales
%
Ventas Internacionales
Presentes en países
Comprometidos
Normativa y Marco Legal
Todos los componentes de AEFA están en posesión de los permisos y licencias legales para ejercer su actividad, y por lo tanto sujetos a los controles del Ministerio de Agricultura.
Desde la natural independencia empresarial por parte de cada uno de los integrantes y dentro de un libre mercado, todos los asociados toman el compromiso de respetar la más pura ética comercial y de fabricación para que el agricultor compre productos de calidad, útiles y rentables para sus cultivos.
Desarrollo y Expansión
AEFA contribuye eficazmente al desarrollo y expansión del sector agrícola.
Los equipos técnicos de cada empresa por separado y en ocasiones conjuntamente actúan en tareas de investigación que tengan interés y representen importantes mejoras agrícolas. Igualmente los asociados asumen el reto de prestar su apoyo a la nutrición agrícola, actuar con total transparencia ante el agricultor, informarle y colaborar en la mejora y rentabilidad de su producción, a la vez que velar por la Naturaleza y el Medioambiente.
Impacto Internacional
AEFA, destaca el carácter exportador de sus socios, quienes mantienen presencia con sus productos en los mercados internacionales de producción agrícola.
Constituidas y con sede en toda la geografía española (con mayor concentración en el Arco Mediterráneo), las empresas que componen AEFA operan tanto a nivel nacional como internacional, estando presentes en más de 100 países en los cinco continentes.
Sostenibilidad
AEFA trabaja en iniciativas que mejoren la sostenibilidad económica, social y medioambiental de cada una de las empresas asociadas.
El compromiso de AEFA va más allá de la fabricación de productos nutricionales de alta calidad. Debido a la necesidad de una agricultura sostenible, los miembros de AEFA centran sus esfuerzos en la fabricación de productos que permitan alcanzar altos rendimientos con la utilización adecuada y precisa de sus formulados.
AGRO